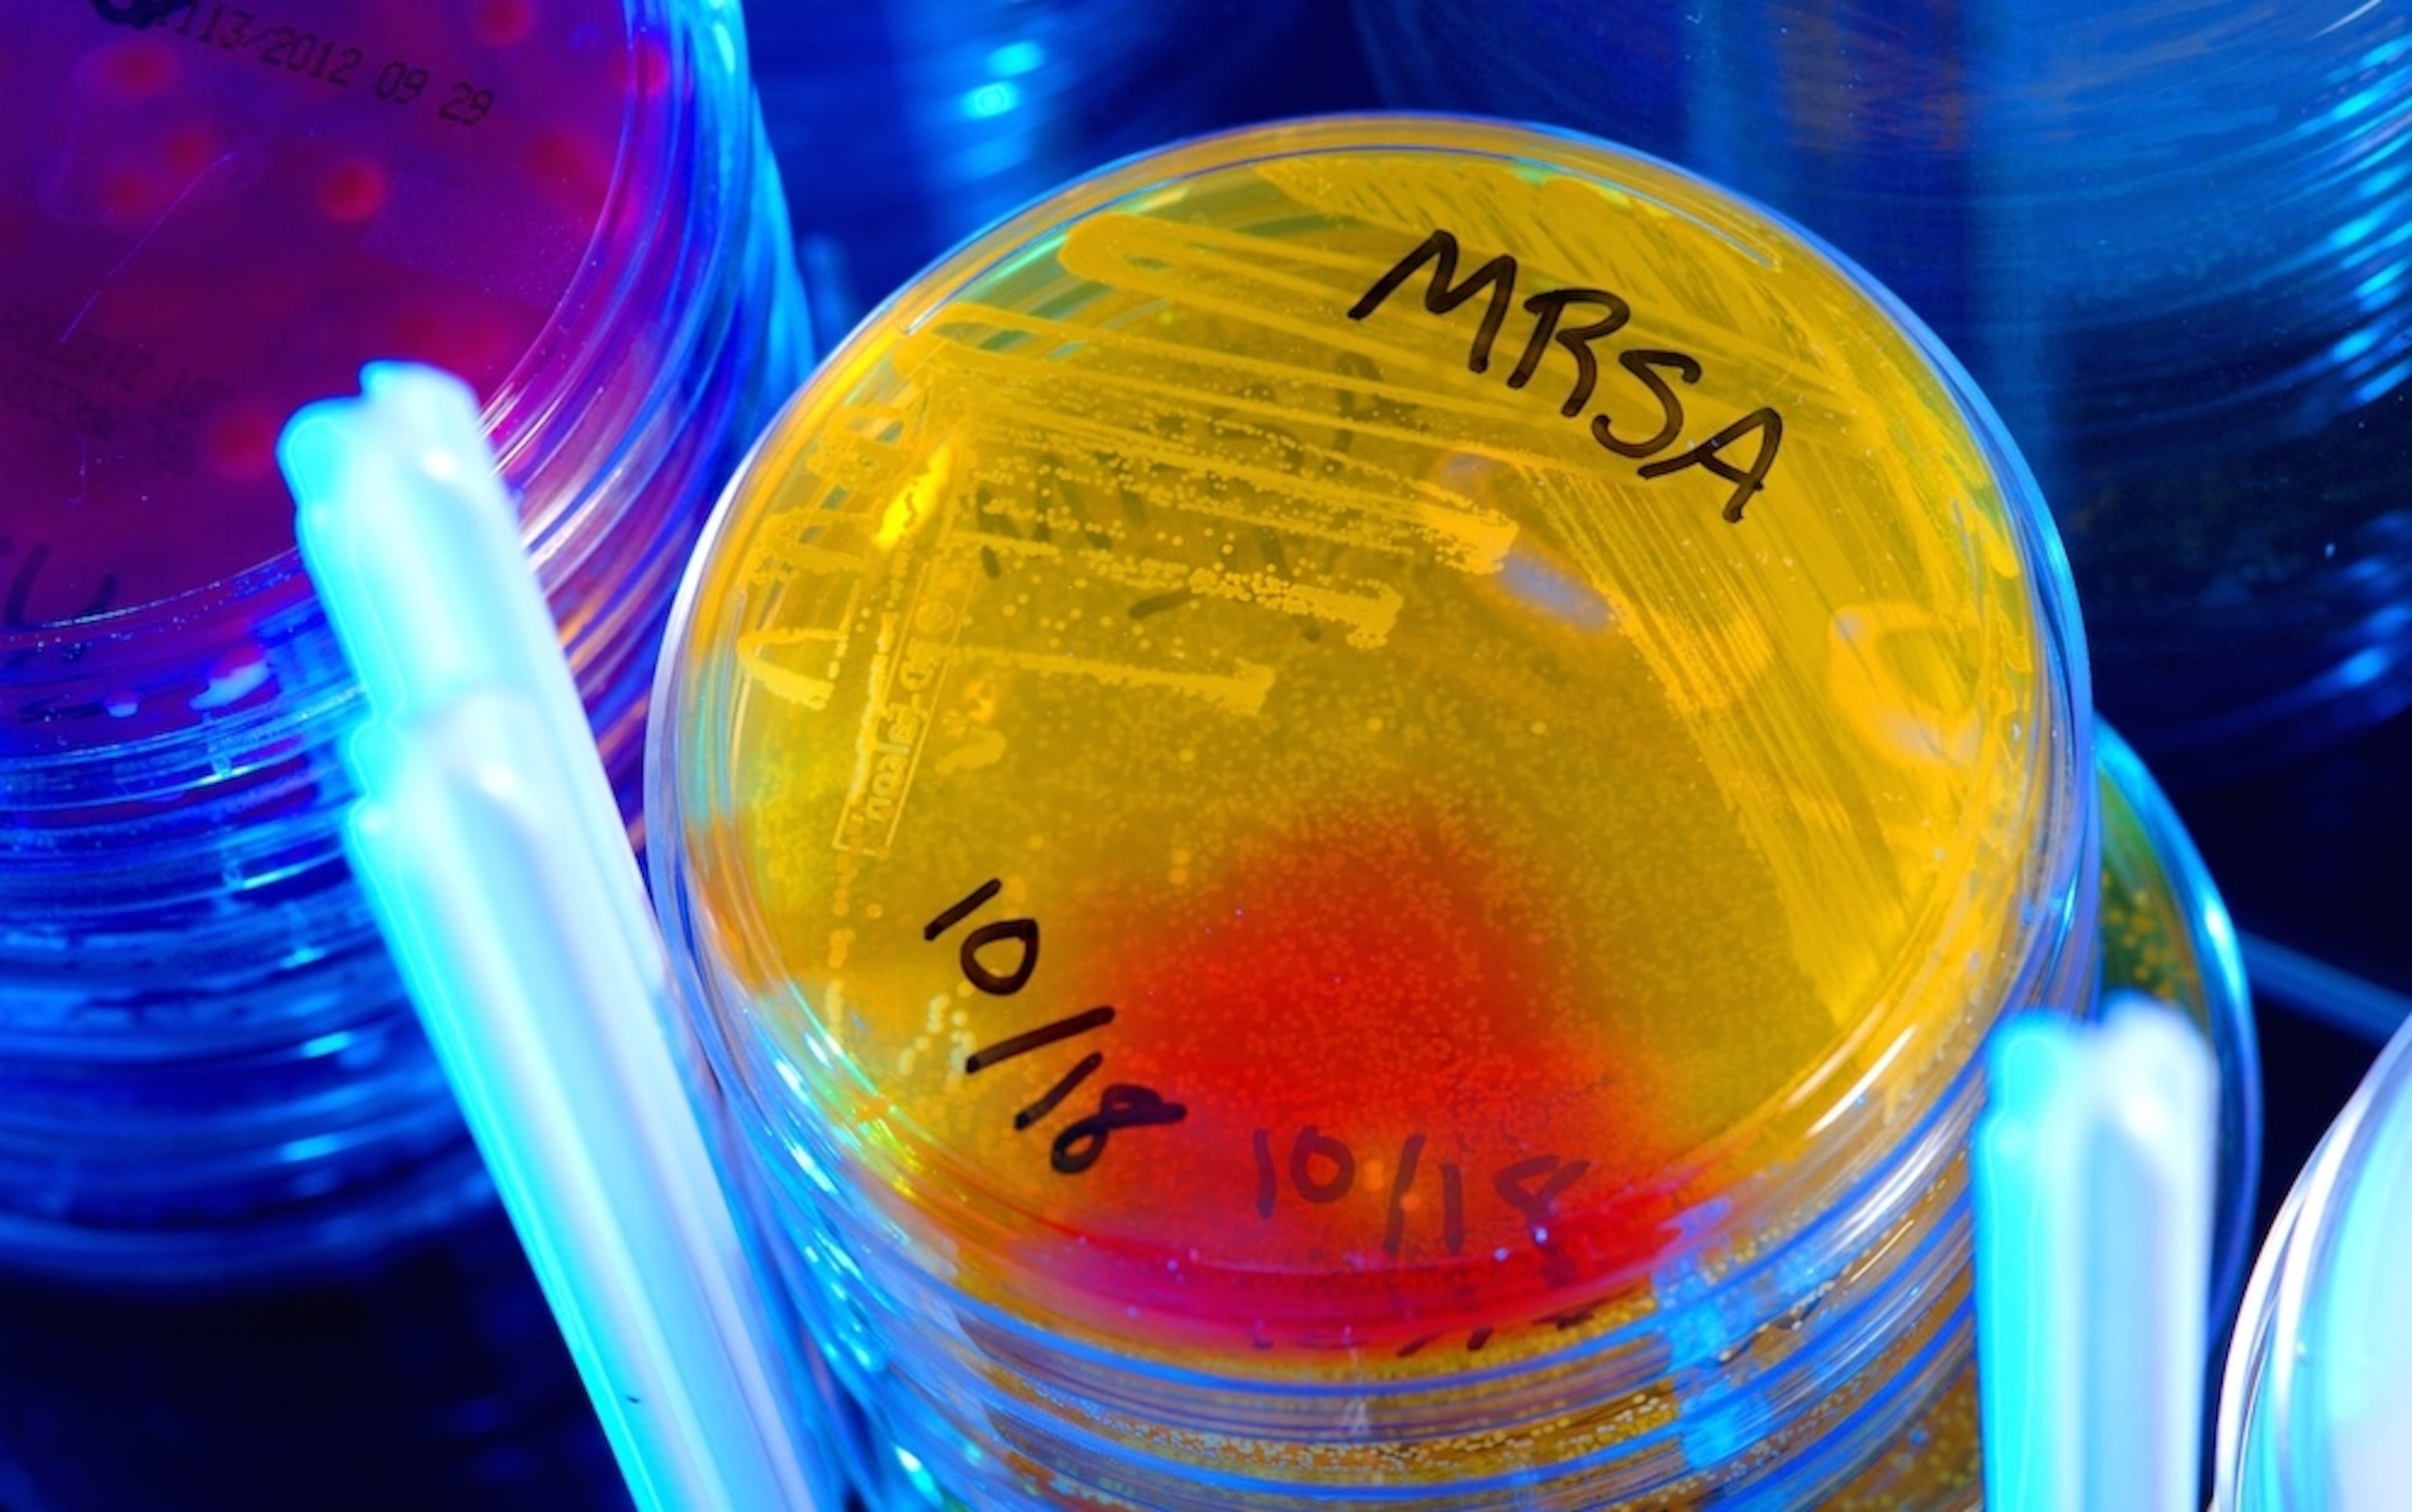

We Need Antibiotics. They’re Not Profitable To Make. Who Pays?
Within the slow-brewing crisis of antibiotic resistance—which according to the Centers for Disease Control and Prevention kills 23,000 Americans each year—there are a lot of failures: of health care personnel who prescribe drugs when they should not; of patients who take drugs badly and encourage resistance to develop; of the drugs themselves, which no longer work against bacteria with toughened defenses. But an important and little-discussed part of the problem is that, once resistance undermines the action of some antibiotics, there are few other drugs to resort to.
If you accept that the antibiotic era began with the first uses of penicillin in 1943, then we had about 65 years of easy access to a pipeline of antibiotics that delivered reliable new cures when resistance made older drugs unreliable. And then, fairly suddenly, we didn’t. About 2000, numerous companies withdrew from antibiotic manufacturing, and the number of new antibiotics in development dropped from dozens to three.

That decision not to make antibiotics actually makes sense. Antibiotics are taken for relatively short courses, unlike cancer or heart-disease drugs, and they are sold for relatively low prices, compared for instance to cancer drugs. Moreover, resistance begins to develop as soon as antibiotics are used—unless a new antibiotic is considered so precious that it is instead reserved for the most last-resort cases. (In that case, it stimulates neither resistance nor income.) For all those reasons, not making antibiotics is a rational choice for a private company that answers to shareholders and analysts, even if that choice deprives the wider world of a wider good.
Thus, getting pharma manufacturers back into antibiotic development is considered a crucial step in combatting resistance. The Infectious Diseases Society of America identified it as a key policy issue more than 10 years ago. It’s been the subject of two separate pieces of legislation, the GAIN Act of 2012 and the ADAPT Act of 2013. And just what incentives should be offered to companies to bring them back to the market is a matter of intense debate, captured in this issue brief by the Center for Disease Dynamics, Economics and Policy and this Chatham House analysis by Kevin Outterson of Boston University. Researchers have proposed price hikes, patent extensions, prizes, up-front payments, and a variety of other incentives to persuade companies to make antibiotics again.
The necessity of new drugs and the puzzle of how to get anyone to produce them has now been taken up by the Review on Antimicrobial Resistance, a two-year project commissioned by the British government and headed by Jim O’Neill, an economist and former chairman of Goldman Sachs Asset Management. The project has previously analyzed the global financial impact of resistance and the crucial need for more research investment (my posts about those reports are here and here), and now turns to the problem of the antibiotic pipeline.
For anyone interested in why the antibiotics market has broken down, the report’s analysis provides a great short course. For instance, it pinpoints the mismatch between R&D investment and recouped costs, as in this graphic:

To counter grave multi-drug resistant threats, the report estimates that we need 15 new antibiotics over 10 years, of which four would have to be truly new formulas (two broad-spectrum, or capable of attacking a number of bacteria, and two narrow-spectrum), while the remainder could be incremental improvements on existing formulas. It estimates the effort would require between $16 billion and $37 billion over that decade—huge amounts, but as the report points out, the global market for antibiotics now earns $40 billion every year, while resistance costs just the United States $20 billion per year in excess healthcare costs.
The report recommends those funds—gathered from a mix of governments and companies—be spent in three ways: to support early-stage research with a “global innovation fund”; smooth the past from bench to product with middle-stage research partnerships; and guarantee a market for the drugs that result, by buying them from the companies via substantial up-front payments separate from any earnings the new drugs might produce.
That last proposal, which falls in a category of incentive known as “delinkages,” is bold, and likely to be controversial. The authors write:
Given the difficulty in significantly curtailing use while there is an incentive for drug companies to sell more drugs, and in the face of weak market incentives for private companies to undertake research into areas that society needs but that are not profitable, we believe that a successful intervention must partially or fully ‘de-link’ profit from sales. This means that one or several lump sums would be paid to the developer regardless of how many courses of drugs are sold.
The payments, they predict, could be up to $2 billion at a time.
If that made you suck in your breath, you’re not alone. In a post, antibiotics consultant and former pharma executive Dr. David Shlaes (whose book Antibiotics: The Perfect Storm is an extended analysis of this market failure) applauds the first two measures and dismisses the third as a nonstarter. He writes that no government or nongovernmental body would be willing to take it on :
O’Neill suggests a global buyer provide somewhere in the range of $1-3 billion as an upfront payment for an appropriate new antibiotic. The global buyer, by such a purchase, would immediately provide a significant return on investment to the company that developed the antibiotic. The buyer would then distribute the drug according to demand and need and would monitor usage… The obvious problem with this is to try and designate such a global buyer who could actually coordinate distribution and use on a global scale. The only entities I know who come close to this are pharmaceutical companies… Governments are notoriously useless here to say nothing of WHO or the UN or the EU.
…the report is a good one in terms of the monetary figures proposed. [I]n terms of practical implementation, we seem to still be in Neverland.
Delinkages have received support from other analysts—but the key question, as Shlaes smartly points out, is who would actually write the check. Out of the large economies, the US and UK have shown the most policy interest in antibiotic resistance, and the most willingness to at least begin to combat it. But the UK has just elected a fiscally conservative government, and the US has an all-consuming election season beginning far too soon. It’s worth hoping that significant spending might be undertaken for this crucial public need. But it’s an open question whether it will.